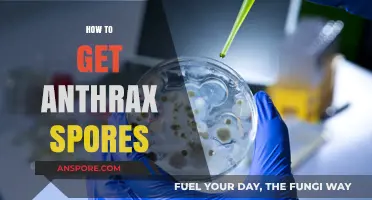
Understanding Anthrax Spores: Safe Research and Detection Methods Explained

Creating an economically thriving city in *Spore* requires a strategic approach to resource management, population growth, and infrastructure development. Players must focus on balancing residential, commercial, and industrial zones to ensure a steady income and meet the needs of their citizens. Efficient transportation networks, such as roads and public transit, are essential to connect these zones and maximize productivity. Additionally, investing in entertainment and healthcare facilities boosts citizen happiness, which in turn increases the city’s economic output. Players should also prioritize exporting surplus resources and importing necessary goods to maintain a healthy trade balance. By carefully planning and adapting to the city’s evolving needs, players can build a prosperous and sustainable economic hub in *Spore*.
| Characteristics | Values |
|---|---|
| Population Density | High (aim for at least 100,000 population) |
| Specialization | Focus on one primary industry (Manufacturing, Entertainment, or Religious) |
| Buildings | |
| - Residential | High-density housing (High-Rise Apartments, Tenements) |
| - Commercial | Shops, Malls, Offices |
| - Industrial | Factories, Warehouses (specific to chosen specialization) |
| Transportation | Efficient network: Roads, Railways, Airports, Seaports |
| Education | Universities, Schools to attract skilled workers |
| Healthcare | Hospitals, Clinics to maintain a healthy workforce |
| Happiness | Parks, Entertainment venues, low crime rate |
| Taxes | Balanced taxation to encourage growth without burdening citizens |
| Trade | Establish trade routes with other cities and nations |
| Sustainability | Consider eco-friendly buildings and practices to avoid pollution penalties |
Explore related products
$14.99 $29.99
What You'll Learn
- Strategic Urban Planning: Optimize land use, infrastructure, and zoning for efficient growth and resource allocation
- Attracting Foreign Investment: Offer incentives, streamline regulations, and enhance global business partnerships
- Sustainable Development: Promote green initiatives, renewable energy, and eco-friendly urban solutions
- Workforce Upskilling: Invest in education, training, and innovation to boost productivity and competitiveness
- Transportation Networks: Develop efficient, affordable, and interconnected public transport systems for seamless mobility

Strategic Urban Planning: Optimize land use, infrastructure, and zoning for efficient growth and resource allocation
Efficient land use is the cornerstone of economic urban development in *Spore*. By maximizing the utility of every square meter, cities can support higher populations, diverse industries, and sustainable growth. Start by prioritizing mixed-use zoning, blending residential, commercial, and recreational spaces to reduce sprawl and minimize transportation needs. For instance, a single city block could house apartments, retail shops, and a public park, creating a self-sustaining micro-economy. This approach not only conserves land but also fosters vibrant, walkable communities that attract both residents and businesses.
Infrastructure must be designed with scalability and adaptability in mind. Roads, public transit, and utilities should anticipate future growth while minimizing waste. Implement modular systems, such as expandable transit hubs or upgradable power grids, to avoid costly overhauls later. For example, a city’s central avenue could start as a two-lane road but be designed to accommodate light rail or additional lanes as population density increases. Similarly, water and energy systems should incorporate renewable sources and smart technology to optimize resource allocation, ensuring long-term efficiency and resilience.
Zoning regulations play a critical role in shaping economic vitality. Strict separation of industrial, residential, and commercial zones can stifle innovation and increase commuting times. Instead, adopt flexible zoning policies that encourage clusters of complementary industries. For instance, tech hubs could be located near universities to foster talent pipelines, while manufacturing zones could be integrated with logistics centers to streamline supply chains. This strategic clustering reduces operational costs for businesses and enhances overall productivity, making the city more attractive to investors.
A practical tip for *Spore* players is to use the game’s terrain tools to create natural barriers and corridors that guide development. Rivers, hills, and forests can serve as both aesthetic features and functional boundaries, directing growth into efficient patterns. For example, a river can act as a transportation artery for trade while also separating industrial areas from residential zones, minimizing pollution impact. By leveraging the environment in this way, players can achieve organic, sustainable growth that mirrors real-world urban planning principles.
Finally, monitor resource consumption and population density in real-time to make data-driven adjustments. Overcrowded areas may require vertical expansion through high-rise buildings, while underutilized zones could benefit from targeted incentives, such as tax breaks for businesses or subsidies for public amenities. Regularly reassess infrastructure needs and reallocate resources to emerging growth centers. This dynamic approach ensures that the city remains economically vibrant and adaptable, capable of thriving in an ever-changing environment.
Can Apple Cider Vinegar Effectively Eliminate Mold Spores? Find Out
You may want to see also

Attracting Foreign Investment: Offer incentives, streamline regulations, and enhance global business partnerships
Foreign investment is the lifeblood of any aspiring economic powerhouse, and Singapore’s success as a global financial hub offers a blueprint for others. At its core, attracting foreign capital requires a trifecta of incentives, regulatory efficiency, and strategic partnerships. Tax breaks, for instance, are a proven magnet: Singapore’s corporate tax rate of 17%, coupled with exemptions for new startups and pioneer industries, has lured multinationals like Shell and Unilever. However, incentives alone aren’t enough. Streamlined regulations—such as Singapore’s 2.5-day business registration process compared to the global average of 11 days—eliminate friction, signaling a business-friendly environment. Meanwhile, global partnerships, exemplified by Singapore’s 20 free trade agreements, amplify its appeal by granting investors access to broader markets.
Consider the instructive case of Ireland, which transformed its economy by offering a 12.5% corporate tax rate and investing in education to create a skilled workforce. While effective, this approach risks over-reliance on a single incentive. Singapore diversifies by layering incentives: grants for R&D (up to 50% of qualifying expenses), co-funding for innovation projects, and subsidies for hiring local talent. For cities aiming to replicate this, start by auditing existing tax structures and identifying sectors ripe for targeted incentives. Pair these with a regulatory overhaul: digitize approvals, adopt a single-window clearance system, and benchmark against global leaders like Denmark, where starting a business takes just 3.5 days.
Persuasion hinges on demonstrating tangible returns. A city’s pitch must highlight not just cost savings but also long-term growth opportunities. For instance, Singapore’s Global Investor Programme offers permanent residency to investors meeting specific criteria—a powerful retention tool. Similarly, co-branding initiatives, such as joint ventures with local firms, can mitigate cultural and operational risks for foreign entities. Caution, however, is warranted: over-generous incentives can strain public finances, while lax regulations may erode trust. Balance is key—offer enough to compete but retain fiscal sustainability, and streamline without sacrificing oversight.
Descriptively, imagine a city where a foreign investor can secure a license in hours, not weeks, and access a talent pool fluent in both Mandarin and English. Picture tax holidays for green technologies, aligning economic growth with sustainability goals. Such a city doesn’t just attract investment—it fosters innovation ecosystems. Takeaway: Success lies in creating a seamless, rewarding experience for investors. Incentives must be tailored, regulations must be frictionless, and partnerships must unlock mutual value.
Comparatively, while Dubai offers 0% corporate tax in free zones, its regulatory complexity often deters SMEs. Singapore’s edge lies in its holistic approach: incentives are generous but targeted, regulations are efficient yet robust, and partnerships are strategic yet inclusive. Cities aiming to replicate this model should study Singapore’s data-driven approach—its Economic Development Board continuously analyzes global trends to refine policies. Practical tip: Start small, perhaps by piloting a one-stop business portal or offering tax credits for job creation in underserved sectors. Scale only after proving efficacy.
In conclusion, attracting foreign investment isn’t about outbidding competitors but outsmarting them. Singapore’s playbook—incentives, streamlined regulations, and global partnerships—offers a replicable framework. However, adaptation is essential. What works in a city-state may require modification in a larger, more diverse economy. The ultimate goal? To become not just a destination for capital, but a catalyst for collaborative growth.
Does Milky Spore Effectively Control Grubs in Colorado Lawns?
You may want to see also

Sustainable Development: Promote green initiatives, renewable energy, and eco-friendly urban solutions
Singapore's urban density demands innovative solutions to balance economic growth with environmental sustainability. Green initiatives aren't just feel-good measures; they're strategic investments in the city's long-term resilience and competitiveness.
Imagine a city where rooftop gardens cool buildings naturally, reducing reliance on energy-guzzling air conditioning. Picture solar panels integrated seamlessly into skyscrapers, harnessing the equatorial sun's power. These aren't futuristic fantasies; they're achievable realities through targeted policies and public-private partnerships.
Implementing a comprehensive green building code is a cornerstone. Mandate minimum energy efficiency standards, incentivize the use of recycled materials, and prioritize designs that maximize natural light and ventilation. Offer tax breaks and grants to developers who incorporate green roofs, vertical gardens, and rainwater harvesting systems. These measures not only reduce the carbon footprint of buildings but also create new job opportunities in green construction and maintenance.
Think of it as a win-win: a healthier environment and a thriving green economy.
Renewable energy sources are no longer a niche market; they're a necessity. Singapore's limited landmass poses a challenge, but innovative solutions exist. Explore floating solar farms on reservoirs, a concept already gaining traction in the region. Invest in tidal energy projects, harnessing the power of the surrounding seas. While initial costs may be higher, the long-term benefits of energy security and reduced reliance on fossil fuels are undeniable.
Sustainable transportation is another crucial piece of the puzzle. Expand the already impressive public transport network, making it even more efficient, affordable, and accessible. Encourage the adoption of electric vehicles through subsidies and charging infrastructure development. Implement congestion pricing to discourage private car usage in congested areas, reducing emissions and improving air quality. Imagine a city where walking, cycling, and public transport are the preferred choices, not just alternatives.
The result? A cleaner, healthier, and more livable urban environment.
Finally, foster a culture of sustainability among residents. Educate citizens about the importance of waste reduction, recycling, and responsible consumption. Implement community-based initiatives like composting programs and urban farming projects. Empower individuals to make sustainable choices in their daily lives, from using reusable bags to supporting local businesses that prioritize eco-friendly practices. By engaging the community, Singapore can create a collective sense of responsibility for the environment, ensuring the long-term success of its green initiatives.
Stream Fox Sports Easily: A Step-by-Step Guide for Fans
You may want to see also
Explore related products
$34.99 $50
$9.15 $29.99

Workforce Upskilling: Invest in education, training, and innovation to boost productivity and competitiveness
A skilled workforce is the backbone of any thriving economy, and Singapore’s journey to becoming an economic powerhouse underscores this truth. To replicate this success, cities must prioritize workforce upskilling as a strategic imperative. This involves more than just traditional education; it requires a holistic approach that integrates training, innovation, and adaptability. For instance, Singapore’s SkillsFuture program offers subsidies for courses ranging from digital literacy to advanced manufacturing, ensuring workers remain relevant in a rapidly evolving job market. Such initiatives not only enhance individual productivity but also elevate the city’s global competitiveness.
Consider the practical steps cities can take to implement effective upskilling programs. First, identify high-demand industries and tailor training to meet their needs. For example, a city with a growing tech sector could partner with universities and companies to offer certifications in AI, cybersecurity, or data analytics. Second, leverage technology to make learning accessible. Online platforms like Coursera or Udemy can provide flexible, affordable courses for workers of all ages. Third, incentivize participation through tax breaks or direct subsidies for both employers and employees. A case in point is Germany’s "Qualifizierungschancengesetz," which funds up to 100% of training costs for SMEs, ensuring even smaller businesses can upskill their workforce.
However, upskilling is not without challenges. One common pitfall is the mismatch between training programs and actual job requirements. To avoid this, cities should foster collaboration between educational institutions and industry leaders to co-create curricula. Another issue is resistance from workers, particularly older employees, who may fear technological displacement. Address this by framing upskilling as a pathway to career longevity rather than a threat. For example, Singapore’s Career Trial Programme allows workers to test new roles before committing, reducing anxiety and increasing buy-in.
The return on investment in workforce upskilling is undeniable. A McKinsey study found that companies prioritizing reskilling see a 12% increase in productivity and a 25% boost in employee retention. On a city-wide scale, this translates to higher GDP growth, reduced unemployment, and a more resilient economy. Take the example of Pittsburgh, which transformed from a declining steel town into a tech hub by investing in STEM education and retraining programs. Similarly, cities aiming to emulate Singapore’s success must view upskilling not as an expense but as a strategic asset.
In conclusion, workforce upskilling is not a one-size-fits-all solution but a dynamic process requiring continuous innovation and adaptation. Cities must act as facilitators, creating ecosystems where education, industry, and technology converge to empower workers. By doing so, they not only enhance productivity and competitiveness but also ensure their economies remain future-proof in an increasingly complex global landscape. The lesson from Singapore is clear: invest in your people, and they will drive your city’s economic success.
Can Vinegar Effectively Kill C. Diff Spores? Facts and Myths
You may want to see also

Transportation Networks: Develop efficient, affordable, and interconnected public transport systems for seamless mobility
Efficient, affordable, and interconnected public transport systems are the lifeblood of any thriving economic city. In Singapore, where land is scarce and population density is high, optimizing mobility isn’t just a convenience—it’s a necessity. The city-state’s Mass Rapid Transit (MRT) system, complemented by buses and light rail, serves as a global benchmark. However, maintaining this edge requires continuous innovation and adaptation. For instance, integrating real-time data analytics can reduce wait times by up to 20%, while dynamic pricing models can incentivize off-peak travel, easing congestion.
To achieve seamless mobility, start by mapping existing transport networks and identifying bottlenecks. Use tools like Geographic Information Systems (GIS) to visualize traffic flow and passenger density. Next, invest in smart infrastructure, such as contactless payment systems and automated fare collection, which can reduce boarding times by 30%. For affordability, consider tiered pricing structures based on income levels or subsidies for low-wage workers. Caution: avoid over-reliance on a single mode of transport; a diversified network ensures resilience during disruptions.
Persuasively, the economic benefits of robust public transport are undeniable. A well-connected system reduces reliance on private vehicles, cutting carbon emissions by an estimated 15% annually. It also boosts productivity by saving commuters up to 10 hours per month, time that can be reinvested into work or leisure. Cities like Copenhagen and Zurich demonstrate that high public transport usage correlates with higher GDP per capita. Singapore can further capitalize on this by expanding its network to underserved areas, fostering inclusive growth.
Comparatively, while Singapore’s MRT is efficient, it lags in last-mile connectivity. Introducing autonomous shuttles or bike-sharing programs can bridge this gap. For example, Helsinki’s bike-sharing system, integrated with its metro, increased overall public transport usage by 12%. Similarly, Singapore could deploy electric scooters in residential areas, ensuring affordability with a pay-per-use model capped at S$2 per ride. Such initiatives not only enhance mobility but also align with sustainability goals.
Descriptively, imagine a morning commute where a resident taps their EZ-Link card at a solar-powered bus stop, receives a notification about the next train’s arrival, and seamlessly transfers to an autonomous shuttle for the final leg. This isn’t science fiction—it’s the future Singapore can achieve by prioritizing interconnectedness. By 2030, the city could aim for a 90% public transport modal share, rivaling Hong Kong’s current 90% rate. The key lies in treating transportation not as isolated projects but as a holistic ecosystem, where every node enhances the whole.
Understanding Spores' Survival Duration: Factors, Conditions, and Longevity Explained
You may want to see also
Frequently asked questions
To build an economic city in Spore, focus on balancing residential, commercial, and industrial zones. Ensure a steady supply of Spice (currency) by connecting your city to trade routes and maintaining a healthy population.
Increase population by providing ample residential space, entertainment (like parks or decorations), and essential services. Happy citizens will reproduce faster, boosting your city's growth.
Trade is crucial for generating Spice. Build trade depots and connect them to roads or ports to export goods. Focus on producing high-demand items to maximize profits.
Organize your city with residential, commercial, and industrial zones close to each other but avoid overlapping to prevent pollution. Use roads to connect zones and ensure easy access to trade routes.
Reduce pollution by placing industrial zones away from residential areas and using decorations like trees or parks to clean the air. Avoid overbuilding industrial zones to maintain a healthy environment.